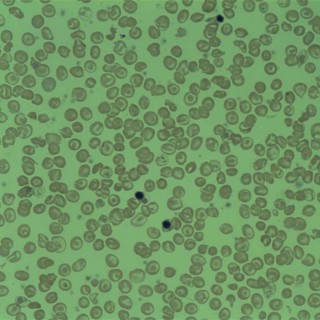

Podcasts about Thalassemia
- 105PODCASTS
- 167EPISODES
- 28mAVG DURATION
- 1MONTHLY NEW EPISODE
- Jan 28, 2026LATEST
POPULARITY
Best podcasts about Thalassemia
Latest news about Thalassemia
- A.P. Red Cross signs MoU to strengthen Thalassemia care The Hindu - National - Jan 13, 2026
- Doctor advises early screening for thalassemia and sickle cell in pregnant women The Hindu - Home - Dec 28, 2025
- Agios Pharmaceuticals secures FDA approval for thalassemia treatment Stocks - Investing.com - Dec 24, 2025
- Exclusive: What the probe into Madhya Pradesh HIV-thalassemia scandal has found so far India | The Indian Express - Dec 19, 2025
- Parents in India devastated as children with thalassemia test HIV positive BBC News - Dec 19, 2025
- Agios Awaits Pyrukynd Decision in Thalassemia as FDA Misses Due Date Zacks Investment Research - All Commentary Articles - Dec 9, 2025
- Agios Provides Update on U.S. sNDA for Mitapivat in Thalassemia GuruFocus New Articles - Dec 8, 2025
- Challenges and opportunities in delivering gene therapies for sickle cell disease and beta thalassemia The Medical News - Dec 7, 2025
- Discovery of a Novel DNMT1 Inhibitor with Improved Efficacy in Treating β‐Thalassemia Wiley: Advanced Science: Table of Contents - Dec 5, 2025
- Zydus gets USFDA's orphan drug designation for beta-thalassemia product Industry-Economic Times - Nov 6, 2025
Latest podcast episodes about Thalassemia
Results from a Global Health Literacy Survey in Thalassemia
On this episode of Thal Pals: The Alpha Beta Revolution, NinaMaria Badalamenti and Dr. Kevin Kuo sit down with two giants in the thalassemia field, Dr. Sujit Sheth and Dr. Nica Cappellini, to unpack findings from a new global health literacy survey. The conversation explores why patient understanding of hemoglobin levels, monitoring, and treatment goals remains so critical, whether someone lives with transfusion-dependent or non-transfusion-dependent thalassemia. Through personal stories and decades of expertise, the guests illuminate how far care has come, where gaps remain, and what true collaboration between patients and clinicians can look like. It's an insightful and empowering discussion for anyone impacted by thalassemia. To read A White Paper on Global Health Literacy in Thalassemia, click here. SHOW DESCRIPTION Thal Pals: The Alpha Beta Revolution Podcast is intended for patients, caregivers, providers, and the greater community of people who are impacted by thalassemia. Each episode strives to provide listeners with critical education, the latest scientific updates, and voices from the thalassemia community. Learn more about thalassemia by visiting RethinkThalassemia.com. Join an inclusive community and build connections with other hemolytic anemia allies by following @AllyVoicesRising on Instagram. Thal Pals is sponsored by Agios Pharmaceuticals Inc. Visit Agios.com to learn more. This podcast is intended for informational and educational purposes only and is not intended as medical advice. Please speak with your healthcare professional before making any treatment decisions. TRANSPARENCY STATEMENT Thal Pals: The Alpha Beta Revolution Podcast is made possible by Agios Pharmaceuticals Inc. Visit Agios.com to learn more. The following Agios-supported programs are intended for informational and educational purposes only and are not intended as medical advice. Please speak with your healthcare professional before making any treatment decisions. Hosts and guests featured in this episode have been compensated for their time.
Thalassemia Myth-Busting: Part 2 – Complications, Exercise, & Transfusions
In part two of their myth-busting series, NinaMaria Badalamenti and Dr. Kevin Kuo continue to break down common misconceptions about thalassemia. They discuss the risks and complications for both alpha and beta thalassemia, the importance of individualized care, and why physical activity is encouraged for people living with the condition. The episode also covers genetic inheritance, the realities of transfusion schedules, and the need for patients to advocate for themselves. Tune in for practical insights and empowering advice for the thalassemia community! SHOW DESCRIPTION Thal Pals: The Alpha Beta Revolution Podcast is intended for patients, caregivers, providers, and the greater community of people who are impacted by thalassemia. Each episode strives to provide listeners with critical education, the latest scientific updates, and voices from the thalassemia community. Learn more about thalassemia by visiting RethinkThalassemia.com. Join an inclusive community and build connections with other hemolytic anemia allies by following @AllyVoicesRising on Instagram. Thal Pals is sponsored by Agios Pharmaceuticals Inc. Visit Agios.com to learn more. This podcast is intended for informational and educational purposes only and is not intended as medical advice. Please speak with your healthcare professional before making any treatment decisions. TRANSPARENCY STATEMENT Thal Pals: The Alpha Beta Revolution Podcast is made possible by Agios Pharmaceuticals Inc. Visit Agios.com to learn more. The following Agios-supported programs are intended for informational and educational purposes only and are not intended as medical advice. Please speak with your healthcare professional before making any treatment decisions. Host and guest featured in this episode have been compensated for their time.
Jharkhand HIV infection case, Goa's tourism woes, and Trump-Xi meet
First, we talk to The Indian Express' Shubham Tigga about a case that has emerged in Jharkhand, where five children suffering from Thalassemia went for their regular blood transfusion and came back HIV positive. He talks about the state government's reaction, the hospital's response and the investigation that is happening. Next, we talk to The Indian Express' Pavneet Singh Chadha about the concerns around tourism in Goa. Since a social media controversy broke out last year about Goa's tourism infrastructure, the tourism stakeholders of the state have been concerned about the footfall during its peak tourist season. (13:40)Lastly, we talk about Chinese President Xi Jinping meeting US President Donald Trump on the sidelines of the Asia Pacific Economic Cooperation Summit in South Korea. (26:35)Hosted by Niharika NandaProduced by Niharika Nanda, Ichha Sharma, and Shashank BhargavaEdited and mixed by Suresh Pawar
Thalassemia Myth-Busting: Part 1 – Fatigue, Hemoglobin & Iron Levels
In this episode of Thal Pals: The Alpha Beta Revolution, hosts NinaMaria Badalamenti and Dr. Kevin Kuo tackle common myths and misconceptions about thalassemia. They discuss the importance of communicating symptoms like fatigue to healthcare providers, the complex relationship between hemoglobin levels and how patients feel, and the realities of iron overload for both transfusion-dependent and non-transfusion-dependent individuals. The episode also explains why ferritin isn't the only important measure of iron overload and uses memorable analogies to make these concepts clear. Tune in for part one of this myth-busting series and get ready for more insights in the next episode! SHOW DESCRIPTION Thal Pals: The Alpha Beta Revolution Podcast is intended for patients, caregivers, providers, and the greater community of people who are impacted by thalassemia. Each episode strives to provide listeners with critical education, the latest scientific updates, and voices from the thalassemia community. Learn more about thalassemia by visiting RethinkThalassemia.com. Join an inclusive community and build connections with other hemolytic anemia allies by following @AllyVoicesRising on Instagram. Thal Pals is sponsored by Agios Pharmaceuticals Inc. Visit Agios.com to learn more. This podcast is intended for informational and educational purposes only and is not intended as medical advice. Please speak with your healthcare professional before making any treatment decisions. TRANSPARENCY STATEMENT Thal Pals: The Alpha Beta Revolution Podcast is made possible by Agios Pharmaceuticals Inc. Visit Agios.com to learn more. The following Agios-supported programs are intended for informational and educational purposes only and are not intended as medical advice. Please speak with your healthcare professional before making any treatment decisions. Host and guest featured in this episode have been compensated for their time.
Navigating Fertility, Pregnancy, & Parenthood with Thalassemia
Hematologist Dr. Arielle Langer joins host NinaMaria Badalamenti to unpack fertility, pregnancy, and family planning for people with thalassemia. From timing and iron control to genetic counseling, birth control options, and postpartum care, this episode offers practical, clear guidance for every stage of the journey. SHOW DESCRIPTION Thal Pals: The Alpha Beta Revolution Podcast is intended for patients, caregivers, providers, and the greater community of people who are impacted by thalassemia. Each episode strives to provide listeners with critical education, the latest scientific updates, and voices from the thalassemia community. Learn more about thalassemia by visiting RethinkThalassemia.com. Join an inclusive community and build connections with other hemolytic anemia allies by following @AllyVoicesRising on Instagram. Thal Pals is sponsored by Agios Pharmaceuticals Inc. Visit Agios.com to learn more. This podcast is intended for informational and educational purposes only and is not intended as medical advice. Please speak with your healthcare professional before making any treatment decisions. TRANSPARENCY STATEMENT Thal Pals: The Alpha Beta Revolution Podcast is made possible by Agios Pharmaceuticals Inc. Visit Agios.com to learn more. The following Agios-supported programs are intended for informational and educational purposes only and are not intended as medical advice. Please speak with your healthcare professional before making any treatment decisions. Host and guest featured in this episode have been compensated for their time.
IAP 384 From Heritage to Hope: Exploring Italian Identity, Thalassemia, and Community Strength
Have you ever wondered how your last name connects to your cultural identity? In this episode, hosts John Viola and Patrick O'Boyle, alongside co-host Dr. Marcella Martin, dive into the deep ties between Italian heritage and personal identity. The conversation takes a powerful turn with guests Janice Cenzoprano and Ralph Colasanti from the Cooley's Anemia Foundation, who guide us through the genetic story of thalassemia. Together, we trace its Mediterranean roots, its links to malaria zones, and even its surprising historical connections to explorers like Marco Polo. Through a moving firsthand account, we hear what it was like to grow up with thalassemia in its early days of treatment — from demanding regimens to the life-changing arrival of oral chelators. Along the way, we highlight the often-unsung community heroes: organizations like Sons of Italy and UNICO, whose unwavering advocacy and support have been vital in this journey. We also revisit the grassroots philanthropy that helped pave the way for today's progress, celebrating figures like Joe Polari and Pat Acasella whose tireless efforts fueled awareness and research. Patient advocacy and breakthroughs in genetic therapy point toward a hopeful future, where advanced treatments could transform patient care. Join us for an episode rich with history, resilience, and community spirit — a testament to how cultural identity and collective action can shape both personal journeys and medical advancement. THEIR SOCIALS Instagram: @cooleysanemia TikTok: tiktok.com/cooleysanemia Facebook: https://www.facebook.com/CooleysAnemiaFoundation X: @cooleysanemia Threads: @cooleysanemia LinkedIn: Cooley's Anemia Foundation THEIR WEBSITE: Thalassmia.org NOTES FROM THE FOUNDATION: Our Thalassemia Care Walk Fundraiser is ongoing throughout the year. Check bit.ly/CAFCareWalk25 for upcoming walks in your city or simply to donate and help us find a universal cure for all patients. Care Walk T-shirts are available at bit.ly/CAFCareWalk25 with registration!
Breaking the Silence: Thalassemia, Stigma & Strength in the Arab Community
In this powerful Arabic-language episode, Dr. Sherif Badawy shares his journey from Egypt to the U.S., his lifelong passion for thalassemia care, and the silent weight of stigma families often carry alone. From gene therapies to community education, this one's about more than medicine—it's about connection. A must-listen for anyone impacted by thalassemia or passionate about rare disease advocacy. SHOW DESCRIPTION Thal Pals: The Alpha Beta Revolution Podcast is intended for patients, caregivers, providers, and the greater community of people who are impacted by thalassemia. Each episode strives to provide listeners with critical education, the latest scientific updates, and voices from the thalassemia community. Learn more about thalassemia by visiting RethinkThalassemia.com. Join an inclusive community and build connections with other hemolytic anemia allies by following @AllyVoicesRising on Instagram. Thal Pals is sponsored by Agios Pharmaceuticals Inc. Visit Agios.com to learn more. This podcast is intended for informational and educational purposes only and is not intended as medical advice. Please speak with your healthcare professional before making any treatment decisions. TRANSPARENCY STATEMENT Thal Pals: The Alpha Beta Revolution Podcast is made possible by Agios Pharmaceuticals Inc. Visit Agios.com to learn more. The following Agios-supported programs are intended for informational and educational purposes only and are not intended as medical advice. Please speak with your healthcare professional before making any treatment decisions. Host and guest featured in this episode have been compensated for their time.
Reviewing Real-World Use of Beti-Cel in Transfusion-Dependent β-Thalassemia
In a special co-branded episode between Oncology On theGo hosted by CancerNetwork® and the American Society for Transplantation and Cellular Therapy (ASTCT)'s program ASTCT Talks, Nora M. Gibson, MD, MSCE, and Taha Al-Juhaishi, MD, spoke about real-world applications of betibeglogene autotemcel (beti-cel; Zynteglo) as a treatment for patients with beta (β)-thalassemia.They spoke in the context of a study that Gibson presented at the 2025 Tandem Meetings, which evaluated patients who received commercial beti-cel in a single-center cohort following the agent's FDA approval in August 2022. ¹ ²Nora is a fourth-year fellow in bone marrow transplant andcellular therapy at the Children's Hospital of Philadelphia (CHOP), with a background in clinical research and epidemiology. Al-Juhaishi is the Associate Director of the Hematopoietic Stem Cell Transplantation and Cell TherapyProgram at Oklahoma University Health Stephenson Cancer Center and an assistant professor of Medicine at the University of Oklahoma College of Medicine.Findings from Gibson's study revealed that among 10 patients who underwent stem cell collection at CHOP from 2022 to 2024, beti-cel yielded consistent red blood cell transfusion independence, with investigators notingprolonged platelet engraftment time and high platelet transfusion requirements. Beyond these findings, the conversation focused on how beti-cel compares withother currently available gene therapies for patients with hemoglobin disorders as well as non-curative therapies like allogeneic stem cell transplantation. Gibson and Al-Juhaishi also discussed strategies for mitigating occlusive disease and other potential toxicities associated with beti-cel.“It's a really exciting time to be working in this fieldwhere we finally have really good options for these patients. From our experience and from clinical trials, beti-cel and likely exagamglogene autotemcel [Casgevy]...are very effective, curative therapies for thalassemia in the real-world setting, and we've seen very similar results in sickle celldisease,” said Gibson. “These therapies have been really life-changing for our patients, and they've had a huge reduction in their symptoms and a huge reduction in their burden of health care that's required.”References1. Gibson NM, Friedman DF, Elgarten CW, et al. Post-approval, real-world experience with betibeglogene autotemcel for transfusion-dependent betathalassemia. Transplantation and Cellular Therapy. 2025;31(2):S254. doi:10.1016/j.jtct.2025.01.386.2. FDA approves first cell-based gene therapy totreat adult and pediatric patients with beta-thalassemia who require regular blood transfusions. News Release. FDA. August 17, 2022. Accessed April 21, 2025.https://tinyurl.com/3vrkk8kz
S1 Ep160: Reviewing Real-World Use of Beti-Cel in Transfusion-Dependent β-Thalassemia
In a special co-branded episode between Oncology On the Go hosted by CancerNetwork® and the American Society for Transplantation and Cellular Therapy (ASTCT)'s program ASTCT Talks, Nora M. Gibson, MD, MSCE, and Taha Al-Juhaishi, MD, spoke about real-world applications of betibeglogene autotemcel (beti-cel; Zynteglo) as a treatment for patients with beta (β)-thalassemia. They spoke in the context of a study that Gibson presented at the 2025 Tandem Meetings, which evaluated patients who received commercial beti-cel in a single-center cohort following the agent's FDA approval in August 2022. Nora is a fourth-year fellow in bone marrow transplant and cellular therapy at the Children's Hospital of Philadelphia (CHOP), with a background in clinical research and epidemiology. Al-Juhaishi is the Associate Director of the Hematopoietic Stem Cell Transplantation and Cell Therapy Program at Oklahoma University Health Stephenson Cancer Center and an assistant professor of Medicine at the University of Oklahoma College of Medicine. Findings from Gibson's study revealed that among 10 patients who underwent stem cell collection at CHOP from 2022 to 2024, beti-cel yielded consistent red blood cell transfusion independence, with investigators noting prolonged platelet engraftment time and high platelet transfusion requirements. Beyond these findings, the conversation focused on how beti-cel compares with other currently available gene therapies for patients with hemoglobin disorders as well as non-curative therapies like allogeneic stem cell transplantation. Gibson and Al-Juhaishi also discussed strategies for mitigating occlusive disease and other potential toxicities associated with beti-cel. “It's a really exciting time to be working in this field where we finally have really good options for these patients. From our experience and from clinical trials, beti-cel and likely exagamglogene autotemcel [Casgevy]...are very effective, curative therapies for thalassemia in the real-world setting, and we've seen very similar results in sickle cell disease,” said Gibson. “These therapies have been really life-changing for our patients, and they've had a huge reduction in their symptoms and a huge reduction in their burden of health care that's required.” References 1. Gibson NM, Friedman DF, Elgarten CW, et al. Post-approval, real-world experience with betibeglogene autotemcel for transfusion-dependent beta thalassemia. Transplantation and Cellular Therapy. 2025;31(2):S254. doi:10.1016/j.jtct.2025.01.386. 2. FDA approves first cell-based gene therapy to treat adult and pediatric patients with beta-thalassemia who require regular blood transfusions. News Release. FDA. August 17, 2022. Accessed April 21, 2025. https://tinyurl.com/3vrkk8kz
Cultural Stigmas and Unity in the Thalassemia Community
On this episode of Thal Pals: The Alpha Beta Revolution, patient advocate NinaMaria discusses the cultural stigmas surrounding thalassemia with three guests, Ralph Colassanti, Radeka Sao, and Erik Phaykeo. Each shares their personal experiences with the condition and the cultural barriers they have faced and overcome. The conversation highlights the importance of community, connection, and empowerment among Thal patients, aiming to break down stigmas and encourage others to share their stories. SHOW DESCRIPTION Thal Pals: The Alpha Beta Revolution Podcast is intended for patients, caregivers, providers, and the greater community of people who are impacted by thalassemia. Each episode strives to provide listeners with critical education, the latest scientific updates, and voices from the thalassemia community. Learn more about thalassemia by visiting RethinkThalassemia.com. Join an inclusive community and build connections with other hemolytic anemia allies by following @AllyVoicesRising on Instagram. Thal Pals is sponsored by Agios Pharmaceuticals Inc. Visit Agios.com to learn more. This podcast is intended for informational and educational purposes only and is not intended as medical advice. Please speak with your healthcare professional before making any treatment decisions. TRANSPARENCY STATEMENT Thal Pals: The Alpha Beta Revolution Podcast is made possible by Agios Pharmaceuticals Inc. Visit Agios.com to learn more. The following Agios-supported programs are intended for informational and educational purposes only and are not intended as medical advice. Please speak with your healthcare professional before making any treatment decisions. Host and guest featured in this episode have been compensated for their time.
Peter Verveniotis and Sally Barton, Thalassaemia and Sickle Cell Australia ( TASCA)
Peter is of Greek descent and shows resilience and strength in facing the challenges of living with Beta Thalassaemia. Peter is passionate about supporting and advocating for others who share his condition. As an Early Childhood teacher, Peter uses his knowledge and personal experiences to assist families navigating the complexities of the health system and accessing vital services. He is a dedicated advocate for patients and the community, providing guidance and support to those in need. Peter enjoys participating in awareness days to educate the community around what it's like living with thalassaemia and to increase awareness of genetic blood conditions. Peter serves as a consumer advisor for the Monash Health Blood Committee, helping to shape policies and initiatives that benefit individuals with blood conditions. Despite some health challenges he faces just like many others living with the condition, Peter remains positive and dedicated to making a difference in the lives of those around him. Sally is an enthusiastic Health Promotions Officer at Thalassaemia and Sickle Cell Australia. She takes great pride in her work as she educates the community about genetic blood conditions, carrier testing and blood donations. She also loves connecting with people, supporting those affected by these conditions. Sally is dedicated to creating a positive impact in the lives of people across Australia. When she's not working, Sally enjoys camping, hiking and being surrounded by nature. She also loves time with family and reading a good book at home Peter Verveniotis, who has been living with thalassemia major for nearly 50 years, and Sally Barton, a health promotions officer at Thalassemia and Sickle Cell Australia. The discussion covers various aspects of thalassemia, including diagnosis, treatment, community attitudes, and future perspectives. Key points include: Peter's experience with regular blood transfusions and the physiological challenges of thalassemia major The impact of diagnosis on family dynamics and community stigma Sally's role in educating high school and university students about thalassemia Advancements in treatment options, including chelation therapy and potential gene therapy The importance of coordinated, multidisciplinary care for thalassemia patients The role of community support in helping patients feel less isolated Proposals for future initiatives, including an international conference and journal editorials The episode provides valuable insights into living with thalassemia and the ongoing efforts to improve care and awareness for this rare genetic condition.
Life with Thalassemia: A Mother's Story
On this episode of Thal Pals, host NinaMaria talks with Maria Saradpan about her experiences as a caregiver to her daughter Camila, who has thalassemia. Maria shares her journey from initial fear and isolation to finding a supportive community and growing relationships with fellow caregivers and patients. The importance of a strong caregiver network, blood donations, and positive experiences at the hospital are highlighted. The episode also features Camila and her sister Mikayla discussing their unique bond and experiences with thalassemia. SHOW DESCRIPTION Thal Pals: The Alpha Beta Revolution Podcast is intended for patients, caregivers, providers, and the greater community of people who are impacted by thalassemia. Each episode strives to provide listeners with critical education, the latest scientific updates, and voices from the thalassemia community. Learn more about thalassemia by visiting RethinkThalassemia.com. Join an inclusive community and build connections with other hemolytic anemia allies by following @AllyVoicesRising on Instagram. Thal Pals is sponsored by Agios Pharmaceuticals Inc. Visit Agios.com to learn more. This podcast is intended for informational and educational purposes only and is not intended as medical advice. Please speak with your healthcare professional before making any treatment decisions. TRANSPARENCY STATEMENT Thal Pals: The Alpha Beta Revolution Podcast is made possible by Agios Pharmaceuticals Inc. Visit Agios.com to learn more. The following Agios-supported programs are intended for informational and educational purposes only and are not intended as medical advice. Please speak with your healthcare professional before making any treatment decisions. Host and guest featured in this episode have been compensated for their time.
Mutations in AMBRA1 aggravate β-thalassemia; targeting MYD88 mutations in lymphomas; air pollution and incident VTE risk
In this week's podcast, a potential new therapeutic target in beta-thalassemia. The E3 ubiquitin ligase AMBRA1 promotes autophagic clearance of free alpha-globin. Researchers describe mutations in the AMBRA1 gene that impair this clearance, exacerbating ineffective erythropoiesis and disease severity. After that: targeting MYD88 mutations. Lasalocid-A is a compound that selectively binds to the MYD88 L265P mutant protein, which is found in a range of B-cell lymphomas. New research shows its potential to inhibit tumor growth, overcome ibrutinib resistance, and synergize with venetoclax. Finally: air pollution is linked to an increased risk of venous thromboembolism in a prospective, community-based cohort study. The findings highlight the harms of pollution, and support the case for global efforts to improve public health.Featured Articles:Mutations in AMBRA1 aggravate β-thalassemia by impairing autophagy-mediated clearance of free α-globinLasalocid A selectively induces the degradation of MYD88 in lymphomas harboring the MYD88 L265P mutationAir pollution is associated with increased risk of venous thromboembolism: the Multi-Ethnic Study of Atherosclerosis
Post-ASH non-malignant highlights: updates in sickle cell disease, thalassemia, and hemophilia
This episode of the VJHemOnc podcast covers updates in non-malignant hematological diseases from the 66th American Society of Hematology (ASH)... The post Post-ASH non-malignant highlights: updates in sickle cell disease, thalassemia, and hemophilia appeared first on VJHemOnc.
Building the Perfect Thalassemia Care Team: Insights from Dr. Sujit Sheth
On this episode of Thal Pals, NinaMaria interviews Dr. Sujit Sheth, a renowned red cell doctor specializing in thalassemia and other red cell disorders. Dr. Sheth emphasizes the importance of assembling a dedicated care team, advocates for patient self-advocacy, and provides valuable insights into individualized patient care. He also discusses the impact of advancements in medical technology and the critical role of continuous communication within care teams. Tune in to learn more about optimizing care for thalassemia patients and the hopeful future of treatment options. SHOW DESCRIPTION Thal Pals: The Alpha Beta Revolution Podcast is intended for patients, caregivers, providers, and the greater community of people who are impacted by thalassemia. Each episode strives to provide listeners with critical education, the latest scientific updates, and voices from the thalassemia community. Learn more about thalassemia by visiting RethinkThalassemia.com. Join an inclusive community and build connections with other hemolytic anemia allies by following @AllyVoicesRising on Instagram. Thal Pals is sponsored by Agios Pharmaceuticals Inc. Visit Agios.com to learn more. This podcast is intended for informational and educational purposes only and is not intended as medical advice. Please speak with your healthcare professional before making any treatment decisions. TRANSPARENCY STATEMENT Thal Pals: The Alpha Beta Revolution Podcast is made possible by Agios Pharmaceuticals Inc. Visit Agios.com to learn more. The following Agios-supported programs are intended for informational and educational purposes only and are not intended as medical advice. Please speak with your healthcare professional before making any treatment decisions. Host and guest featured in this episode have been compensated for their time.
Dual TKI targeting in Ph+ ALL; role of liver endothelial ferroportin in iron sensing and homeostasis; severe anemia in pregnant patients with beta-thalassemia minor
In this week's episode we'll learn about asciminib plus dasatinib in Philadelphia chromosome-positive acute leukemia. In a phase 1 study, combining two tyrosine kinase inhibitors with distinct mechanisms of action had encouraging activity in patients with de novo disease. After that: new research demonstrates that the iron exporter ferroportin contributes to the iron-sensing properties of liver endothelial cells. But is it the primary mediator of systemic iron homeostasis? Finally: anemia in pregnant patients with beta-thalassemia minor. In the third trimester, about one-third of patients have hemoglobin levels of 9 grams per deciliter or lower. This report may help to guide the appropriate diagnosis of anemia while limiting unnecessary testing and interventions. Featured Articles:Asciminib plus dasatinib and prednisone for Philadelphia chromosome–positive acute leukemiaThe hepcidin-ferroportin axis modulates liver endothelial cell BMP expression to influence iron homeostasis in miceβ-Thalassemia minor is associated with high rates of worsening anemia in pregnancy
In this episode I cover the different type so anaemia as I have found it can cause much confusion and there are so many different types, from mild iron deficiency to types that can be life threatening. Iron deficiency anaemia: https://www.nhs.uk/conditions/iron-deficiency-anaemia/Bone marrow: https://my.clevelandclinic.org/health/body/22818-bone-marrowHaem and non haem iron: https://www.mkuh.nhs.uk/patient-information-leaflet/good-sources-of-ironVitamin C and iron: https://www.canr.msu.edu/news/iron_and_vitamin_c_the_perfect_pairAplastic anaemia: https://www.gosh.nhs.uk/conditions-and-treatments/conditions-we-treat/aplastic-anaemia/Pernicious anaemia: https://my.clevelandclinic.org/health/diseases/22377-pernicious-anemiaAnaemia of chronic disease: https://my.clevelandclinic.org/health/diseases/14477-anemia-of-chronic-diseaseMCV on a blood count: https://medlineplus.gov/lab-tests/mcv-mean-corpuscular-volume/Leukaemia: https://www.cancerresearchuk.org/about-cancer/leukaemiaHaemolytic anaemia: https://www.hopkinsmedicine.org/health/conditions-and-diseases/hemolytic-anemiaSickle cell disease: https://www.nhs.uk/conditions/sickle-cell-disease/Thalassemia: https://my.clevelandclinic.org/health/diseases/14508-thalassemiasIron diet sheet: https://kingstonhospital.nhs.uk/information/iron-diet-sheet/Eating your greens: https://pubmed.ncbi.nlm.nih.gov/34034049/ Hosted on Acast. See acast.com/privacy for more information.
Navigating Nutrition for Hemolytic Anemias - Part 1
On this episode of Thal Pals, NinaMaria hosts Tamara Schryver, president of the Thrive with Pyruvate Kinase Deficiency Organization. They discuss the importance of nutrition for patients with hemolytic anemias such as thalassemia and PKD. Tamara offers practical dietary tips and emphasizes the significance of nutrient-dense foods and vitamins. Stay tuned for the next episode, where they delve deeper into these topics. SHOW DESCRIPTION Thal Pals: The Alpha Beta Revolution Podcast is intended for patients, caregivers, providers, and the greater community of people who are impacted by Thalassemia. Each episode, Thal Pals strives to provide listeners with critical education, the latest scientific updates, and voices from the Thalassemia community. TRANSPARENCY STATEMENT Thal Pals: The Alpha Beta Revolution Podcast is made possible by Agios Pharmaceuticals Inc. Visit Agios.com to learn more. The following Agios-supported programs are intended for informational and educational purposes only and are not intended as medical advice. Please speak with your healthcare professional before making any treatment decisions. Hosts featured in this episode have been compensated for their time.
Spreading the Word: Lab Tests – Part 2
On this episode of Thal Pals, hosts NinaMaria Badalamenti and Dr. Kevin Kuo delve into the second part of their discussion on lab tests. They explore the impact of factors like menstruation, nutrition, and illness on ferritin levels, and emphasize the importance of monitoring and managing iron levels through diet and medication. They also explain how MRI is used to measure iron accumulation in vital organs such as the liver and heart, the implications of different readings, and the recommended frequency of these tests. The episode concludes with advice on working collaboratively with healthcare providers to keep track of essential lab tests and ensure overall health. SHOW DESCRIPTION Thal Pals: The Alpha Beta Revolution Podcast is intended for patients, caregivers, providers, and the greater community of people who are impacted by Thalassemia. Each episode, Thal Pals strives to provide listeners with critical education, the latest scientific updates, and voices from the Thalassemia community. TRANSPARENCY STATEMENT Thal Pals: The Alpha Beta Revolution Podcast is made possible by Agios Pharmaceuticals Inc. Visit Agios.com to learn more. The following Agios-supported programs are intended for informational and educational purposes only and are not intended as medical advice. Please speak with your healthcare professional before making any treatment decisions. Hosts featured in this episode have been compensated for their time.
Homebirth after a positive hospital birth, alpha-thalassemia, long placenta birth & impact of COVID restrictions || Joey's birth of Avery at home (Australian Capital Territory)
Hello! I would love to hear what your fave part of the ep was. Send me a msg by clicking here :)This is episode 53, and today we hear from Joey in Canberra. Joey is a physio and mum to two boys, Bellamy who she very almost had a homebirth with and Avery, who she did birth at home. Joey shares with us her journey with Bellamy and we reflect on why she chose homebirth, even having had what she describes as a positive hospital birth. We also chat about the impact of COVID on pregnancy, labour and her post partum, and the many things she learnt even as a physio, when researching physiological birth. Resources in this ep: Birth Skills by Juju Sundin https://thememo.com.au/products/birth-skills?srsltid=AfmBOoqvWYN5vby3hUbgVLzxcnvNRHGFSmF9Nzn8OAI0_R1aOB04j7SPCub Birth Stool https://www.cubmama.com/Peaut App https://www.peanut-app.io/Support the showConnect with me, Elsie, the host :) www.birthingathome.com.au @birthingathome_apodcast@birthingathome_a.doula birthingathome.apodcast@gmail.com
Using NGS to refine risk stratification in T-ALL; a novel gene therapy approach in severe α-thalassemia; molecular taxonomy of MDS
In this week's episode we'll learn about refining risk stratification in T-cell acute lymphoblastic leukemia, or ALL. After that, we'll discuss a novel gene therapy approach in severe alpha-thalassemia. Investigators describe an innovative mouse model and an effective gene therapy approach, renewing prospects for the development of novel strategies to treat this disease. Finally, we'll hear about how genomic profiling has helped identify subgroups associated with distinct clinical phenotypes and outcomes in the molecular taxonomy of myelodysplastic syndromes, or MDS. Featured Articles NGS-based stratification refines the risk stratification in T-ALL and identifies a very-high-risk subgroup ofpatientsUse of HSC-targeted LNP to generate a mouse model of lethal α-thalassemia and treatment via lentiviralgene therapyMolecular taxonomy of myelodysplastic syndromes and its clinical implications
How Karma Lebanon Charity is Saving the Children with Dr. Layal Issa
TSC News TV host Fred Richani interviews Dr. Layal Issa MD about her fantastic work with nonprofit organization Karma-Lebanon, which helps children suffering from cancer, thalassemia, and chronic illnesses, especially in these trying times of war. Donate today to support their cause: https://karma-leb.org/?product=donate-to-karma-lebanon Note: This interview was filmed prior to the recent attacks on Lebanon. Follow Karma Lebanon online: https://www.instagram.com/karma.lb/ https://www.facebook.com/karmaleb Karma Lebanon Interview Time Stamps: 00:00 Introducing Dr. Layal Issa of Karma Lebanon charity 00:39 Dr. Layal Issa on Karma Lebanon fundraising campaigns 02:21 Dr. Layal Issa on joining Karma Lebanon, Mariam Younes 03:26 Karma-Lebanon origin story with Mariam Younes 04:24 Dr. Issa explains Thalassemia, treating Lebanese children 07:42 Dr. Issa on challenges Karma-Lebanon faces 10:14 Resources needed to help Lebanese children 12:17 Most prevalent chronic illnesses among Lebanese children 13:26 Why you should donate, volunteer to Karma-Lebanon
Understanding Lab Tests: Hemoglobin and Ferritin Explained – Part 1
On this episode hosts NinaMaria Badalamenti and Dr. Kevin Kuo discuss important lab tests for thalassemia treatment. They focus on hemoglobin, explaining its role in oxygen transportation, the significance of trends over specific numbers, and the differences for transfusion-dependent and non-transfusion-dependent patients. They also introduce ferritin, describing its function, the importance of trends, and the use of MRI for accurate iron measurement. The conversation emphasizes the need for monitoring and understanding lab results in context with patients' overall health and lifestyle. SHOW DESCRIPTION Thal Pals: The Alpha Beta Revolution Podcast is intended for patients, caregivers, providers, and the greater community of people who are impacted by Thalassemia. Each episode, Thal Pals strives to provide listeners with critical education, the latest scientific updates, and voices from the Thalassemia community. TRANSPARENCY STATEMENT Thal Pals: The Alpha Beta Revolution Podcast is made possible by Agios Pharmaceuticals Inc. Visit Agios.com to learn more. The following Agios-supported programs are intended for informational and educational purposes only and are not intended as medical advice. Please speak with your healthcare professional before making any treatment decisions. Hosts featured in this episode have been compensated for their time.
PEDS: Four Gene Alpha Thalassemia
Beyond the Pearls: Cases for Med School, Residency and Beyond (An InsideTheBoards Podcast)
Today's Episode Charlee reviews chapter 14 from the Pediatric Morning Report book. A premature female neonate is born to a G1P0-1 mother at 24 weeks and 5 days gestation with a birth weight of 769g via spontaneous vaginal delivery after preterm onset of labor. The infant requires immediate endotracheal intubation as she is noted to be markedly pale and edematous. Oxygen saturation is in the 60%–70% range. Apgar scores are 1 and 6 at 1 and 5 minutes, respectively. Today's Host Charlee Quarless is a 3rd year medical student at Ross University. About Dr. Raj Dr Raj is a quadruple board certified physician and associate professor at the University of Southern California. He was a co-host on the TNT series Chasing the Cure with Ann Curry, a regular on the TV Show The Doctors for the past 7 seasons and has a weekly medical segment on ABC news Los Angeles. More from Dr. Raj www.BeyondThePearls.net The Dr. Raj Podcast Dr. Raj on Twitter Dr. Raj on Instagram Want more board review content? USMLE Step 1 Ad-Free Bundle Crush Step 1 Step 2 Secrets Beyond the Pearls The Dr. Raj Podcast Beyond the Pearls Premium USMLE Step 3 Review MedPrepTGo Step 1 Questions Learn more about your ad choices. Visit megaphone.fm/adchoices
Live in Atlanta: Thriving with Thalassemia
On this episode of Thal Pals we're live in Atlanta, Georgia for the 2024 Cooley's Anemia Foundation's 2024 Patient-Family Conference. We assembled a panel moderated by Dr. Kevin Kuo and guest host Shae Ghosh. The panel dove into inspiring stories and practical advice from individuals living with thalassemia. Brian Goff, CEO of Agios Pharmaceuticals, opens with a heartfelt introduction, followed by a panel featuring Pranav Saha, Dr. Zahra Pakbaz, and Robert Mannino. Each shares their experiences balancing thalassemia with their personal and professional lives, emphasizing the importance of prioritizing health, being your own advocate, and following your dreams. The panel also discusses the value of learning from one's journey and from others, fostering a community that encourages thriving despite the challenges of thalassemia. SHOW DESCRIPTION Thal Pals: The Alpha Beta Revolution Podcast is intended for patients, caregivers, providers, and the greater community of people who are impacted by Thalassemia. Each episode, Thal Pals strives to provide listeners with critical education, the latest scientific updates, and voices from the Thalassemia community. TRANSPARENCY STATEMENT Thal Pals: The Alpha Beta Revolution Podcast is made possible by Agios Pharmaceuticals Inc. Visit Agios.com to learn more. The following Agios-supported programs are intended for informational and educational purposes only and are not intended as medical advice. Please speak with your healthcare professional before making any treatment decisions. Hosts featured in this episode have been compensated for their time.
Updates in the treatment of SCD and thalassemia from EHA 2024: key trial updates, challenges with gene therapies & unmet needs
Today's VJHemOnc podcast features experts Rabi Hanna, MD, The Cleveland Clinic Taussig Cancer Institute, Cleveland, OH, Subarna Chakravorty, MBBS, MRCPCH,... The post Updates in the treatment of SCD and thalassemia from EHA 2024: key trial updates, challenges with gene therapies & unmet needs appeared first on VJHemOnc.
Iron Will – Management of Iron Overload
On this episode of Thal Pals: The Alpha Beta Revolution, hosts NinaMaria Badalementi and Dr. Kevin Kuo dive into the topic of iron overload, a critical issue for patients with thalassemia. They discuss the body's mechanisms in handling iron, the dangers of iron overload due to blood transfusions, and the importance of chelation therapy. Dr. Kuo emphasizes the need for regular monitoring and patient-doctor collaboration, explaining the potential organ damage caused by excess iron. NinaMaria shares insights on managing one's health and the significance of patient education and communication. The episode highlights the various complications of iron overload, the role of liver and heart MRIs in monitoring, and the importance of adhering to chelation therapy to prevent severe health issues. SHOW DESCRIPTION Thal Pals: The Alpha Beta Revolution Podcast is intended for patients, caregivers, providers, and the greater community of people who are impacted by Thalassemia. Each episode, Thal Pals strives to provide listeners with critical education, the latest scientific updates, and voices from the Thalassemia community. TRANSPARENCY STATEMENT Thal Pals: The Alpha Beta Revolution Podcast is made possible by Agios Pharmaceuticals Inc. Visit Agios.com to learn more. The following Agios-supported programs are intended for informational and educational purposes only and are not intended as medical advice. Please speak with your healthcare professional before making any treatment decisions. Hosts featured in this episode have been compensated for their time.
On this episode of Thal Pals, your host NinaMaria Badalementi, along with special guests Yasmeen and Paris, takes listeners through a detailed discussion about Cooley's Care Walks. We start with Yasmeen and Paris sharing personal experiences with thalassemia, the significance of community, and encouraging participation in Cooley's Care Walks. The episode covers ways to get involved, the impact of fundraising, and the diverse activities surrounding these walks. SHOW DESCRIPTION Thal Pals: The Alpha Beta Revolution Podcast is intended for patients, caregivers, providers, and the greater community of people who are impacted by Thalassemia. Each episode, Thal Pals strives to provide listeners with critical education, the latest scientific updates, and voices from the Thalassemia community. TRANSPARENCY STATEMENT Thal Pals: The Alpha Beta Revolution Podcast is made possible by Agios Pharmaceuticals Inc. Visit Agios.com to learn more. The following Agios-supported programs are intended for informational and educational purposes only and are not intended as medical advice. Please speak with your healthcare professional before making any treatment decisions. Hosts featured in this episode have been compensated for their time.
Ben Carpenter, MD, PhD - Exploring Novel Therapeutic Frontiers in Transfusion-Dependent Beta Thalassemia: The Path to Transfusion Independence
Please visit answersincme.com/VMK860 to participate, download slides and supporting materials, complete the post test, and obtain credit. In this activity, an expert in hematology discusses the use of novel therapies for patients with transfusion-dependent beta thalassemia. Upon completion of this activity, participants should be better able to: Describe the limitations of ongoing transfusions for patients with transfusion-dependent beta thalassemia (TDT); Review the evidence on novel therapies for TDT; and Outline shared decision-making strategies for the potential use of novel therapies for patients with TDT.
Bringing a smile to the faces of children with Thalassemia disease in Duhok
On international Thalassemia Day on 8 May 2024, children with the blood disorder, caused when the body doesn't make enough of a protein called haemoglobin, were treated to a special event as they received gifts and entertainment from many sponsors, particularly Nada Jergis, who has been sponsoring this event for many years. Jergis said she appreciated the donation by some people from Australia when she visited recently. Naseem Sadiq attended the event and filed this report.
Episode 2475: Ralph Colosanti ~ President of the National Cooley's Anemia Board of Director talks HOPE & Mentorship, Breakthrough's & the Future Pt.2
President, National Cooley's Anemia FoundationRalph is BACK!!Cooley's Anemia is a Fatal Genetic Blood Disease. The Cooly's Anemia Foundation is working with medical professionals enhancing the quality of life of patients and educating the medical , trait carriers and the public about Cooley's anemia/thalassemia major.“When I was diagnosed, the outlook was grim, a life expectancy into my late teens, early twenties, with many warning me that living a normal life – having a family, working, living very far into my adult years – was not likely, but faith brought me all that and more. And while there are still many mountains a person with thalassemia has to climb, we now are in a position where a well-managed patient can enjoy many of the same things as a person not living with thalassemia. It's a challenge, but I and others like me have learned to never give up. And definitely don't stop believing!”This episode is dedicated to encourage the Parents, Patients & Loved Ones that are learning about, managing & perservering everyday with Cooley's Anemia, the supporters of Thalassemia, Friends, Researchers & Physicians.. In Addition, this Show is a Dedication to the late Patient Ralph A. Cazzetta. He was a Cooley's Patient, a Nurse, Friend & Great Support Peer to Many in their Life Journey thru thriving as a Thal Patient!! History was made in 2022 at the annual board meeting of the Cooley's Anemia Foundation (CAF) when Ralph Colasanti was elected the first person with thalassemia to serve as National President of the Foundation's board of directors. The Foundation, which was started in 1954, is the primary voice for those with thalassemia, a group of genetic disorders, one of which is also called Cooley's anemia. People with severe forms of the disease require lifelong blood transfusions as often as every 2 weeks and often beginning in infancy.“We are very pleased to have reached this historic moment and know that Ralph's talents, skills, knowledge, and expertise will serve him well in this position,” says Peter Chieco, immediate Past National President of CAF. “Of equal importance, being a patient himself will provide a fresh perspective. No matter how deep the connection that I and our previous Presidents have with the thalassemia community, it is not quite the same experience as actually being a person who was born with and has lived with thalassemia for their entire lives.”“The fact that I am able to serve in this capacity speaks to the tremendous efforts of The Cooley's Anemia Foundation throughout the years,” says Ralph Colasanti. “Those that served before me helped propel many advances in the field of thalassemia over the last 20-30 years. Their commitment, with support from our donors, brought forth dedicated clinicians and researchers who are experts in thalassemia, not only advancing our quantity of life but the most important quality of life. These medical advances and the need for a safe blood supply are tirelessly promoted and supported by CAF.Ralph is a financial coach and IT consultant at Holy Angels School. He and his wife are the parents of a son and a daughter and recently welcomed their first grandchild.© 2024 Building Abundant Success!!2024 All Rights ReservedJoin Me on ~ iHeart Media @ https://tinyurl.com/iHeartBASSpot Me on Spotify: https://tinyurl.com/yxuy23baAmazon Music ~ https://tinyurl.com/AmzBASAudacy: https://tinyurl.com/BASAud
Tin trong nước - Để không còn nỗi đau mang tên “Tan máu bẩm sinh”
- Ngày Thalassemia thế giới (8/5) năm nay có chủ đề: “Tăng cường phổ cập thông tin và tiếp cận dịch vụ về bệnh tan máu bẩm sinh Thalassemia để góp phần nâng cao chất lượng giống nòi Việt”. Với gần 13 triệu người mang gen bệnh Thalassemia, hơn 20 nghìn người bệnh đang cần được điều trị, khoảng 8 nghìn trẻ sinh ra mắc bệnh cần được điều trị suốt đời, đây thực sự là gánh nặng của mỗi gia đình, xã hội khi người thân, con em mình chẳng may mắc căn bệnh này. Để không còn những nỗi đau mang tên tan máu bẩm sinh Thalassemia, một số cơ sở y tế đã triển khai rộng rãi các xét nghiệm tầm soát nhằm sàng lọc căn bệnh này với các cặp vợ chồng trong độ tuổi sinh sản. Đây cũng là một chủ trương mà ngành y tế đang khuyến khích nhằm loại bỏ căn bệnh nguy hiểm đang có nguy cơ gia tăng tại nước ta. --- Support this podcast: https://podcasters.spotify.com/pod/show/vov1tintuc/support
Episode 2464: Ralph Colosanti ~ President of the National Cooley's Anemia Board of Director talks about Maintaining Success thru Life's Triumph's & Challenges Pt.1
President, National Cooley's Anemia FoundationCooley's Anemia is a Fatal Genetic Blood Disease. The Cooly's Anemia Foundation is working with medical professionals enhancing the quality of life of patients and educating the medical , trait carriers and the public about Cooley's anemia/thalassemia major.This episode is dedicated to encourage the Parents, Patients & Loved Ones that are learning about, managing & perservering everyday with Cooley's Anemia, the supporters of Thalassemia, Friends, Researchers & Physicians.. In Addition, this Show is a Dedication to the late Patient Ralph A. Cazzetta. He was a Cooley's Patient, a Nurse, Friend & Great Support Peer to Many in their Life Journey thru thriving as a Thal Patient!! History was made in 2022 at the annual board meeting of the Cooley's Anemia Foundation (CAF) when Ralph Colasanti was elected the first person with thalassemia to serve as National President of the Foundation's board of directors. The Foundation, which was started in 1954, is the primary voice for those with thalassemia, a group of genetic disorders, one of which is also called Cooley's anemia. People with severe forms of the disease require lifelong blood transfusions as often as every 2 weeks and often beginning in infancy.“We are very pleased to have reached this historic moment and know that Ralph's talents, skills, knowledge, and expertise will serve him well in this position,” says Peter Chieco, immediate Past National President of CAF. “Of equal importance, being a patient himself will provide a fresh perspective. No matter how deep the connection that I and our previous Presidents have with the thalassemia community, it is not quite the same experience as actually being a person who was born with and has lived with thalassemia for their entire lives.”“The fact that I am able to serve in this capacity speaks to the tremendous efforts of The Cooley's Anemia Foundation throughout the years,” says Ralph Colasanti. “Those that served before me helped propel many advances in the field of thalassemia over the last 20-30 years. Their commitment, with support from our donors, brought forth dedicated clinicians and researchers who are experts in thalassemia, not only advancing our quantity of life but the most important quality of life. These medical advances and the need for a safe blood supply are tirelessly promoted and supported by CAF.“When I was diagnosed, the outlook was grim, a life expectancy into my late teens, early twenties, with many warning me that living a normal life – having a family, working, living very far into my adult years – was not likely, but faith brought me all that and more. And while there are still many mountains a person with thalassemia has to climb, we now are in a position where a well-managed patient can enjoy many of the same things as a person not living with thalassemia. It's a challenge, but I and others like me have learned to never give up. And definitely don't stop believing!”Ralph is a financial coach and IT consultant at Holy Angels School. He and his wife are the parents of a son and a daughter and recently welcomed their first grandchild.© 2024 Building Abundant Success!!2024 All Rights ReservedJoin Me on ~ iHeart Media @ https://tinyurl.com/iHeartBASSpot Me on Spotify: https://tinyurl.com/yxuy23baAmazon Music ~ https://tinyurl.com/AmzBASAudacy: https://tinyurl.com/BASAud
Ever wondered if there's more to your fatigue than meets the eye? Join Professor Jonathan Sackier and Dr. Nigel Guest as they guide you through the world of anaemia… from the esoteric to the bleeding obvious.From the basics of red blood cell deficiency to the intricacies of different symptoms, they're here to shed light on this commonly underestimated condition.Repair to anaemia, where Professor Sackier enlightens us as to the various types and their unique characteristics. From bleeding-related anaemia to the complexities of chronic causes and blood disorders, Dr. Guest delves into the diagnostic realm, unveiling the array of methods used to detect anaemia. From comprehensive medical histories to physical examinations and full blood counts, discover the tools that aid in uncovering this silent blood thief.The conversation takes a turn when The Docs stumble upon a rare and blood-curdling case of auto-vampirism, where an individual was found to be consuming their own blood—talk about a blood thirsty situation! Lucky Nigel carries garlic wherever he goes. Well... he smells like he does!They will chat about treatment and management strategies and explore the role of iron supplementation and folic acid during pregnancy, vital for maintaining healthy blood levels and preventing complications. You will hear about some strange cravings caused by anaemia, come might call it rocket science! Or arugula science for our American listeners. Dive deeper into the realm of genetic anomalies with discussions on sickle cell disease, thalassemia, and emerging gene editing techniques. But how are advancements in modern medication reshaping anaemia treatment? You'll find all of this out, and more, in this week's episode.If you want to read more info about this week's episode, head on over to the website where Jonathan goes into more detail here.—--DISCLAIMER: The views and opinions expressed on Join the Docs are those of Dr. Nigel Guest, Jonathan Sackier and other people on our show. Be aware that Join the Docs is not intended to be medical advice, it is for information and entertainment purposes only - please, always take any health concerns to your doctor or other healthcare provider. We respect the privacy of patients and never identify individuals unless they have consented. We may change details, dates, place names and so on to protect privacy. Listening to Join the Docs, interacting on our social media, emailing or writing to us does not establish a doctor patient relationship. To Contact Us: For a deeper dive on this episode's issue, merchandise and exclusive content, head to www.jointhedocs.comFollow us on youtube.com/JoinTheDocs Follow us on instgram.com/JoinTheDocsFollow us on tiktok.com/JoinTheDocsFollow us on facebok.com/JoinTheDocs Follow us on x.com/JoinTheDocs
How PAR2 signaling drives thrombo-inflammation; pretransfusion hemoglobin levels linked to survival in beta-thalassemia; etoposide is better than its reputation in primary HLH
In this week's episode we'll discuss PAR2-biased signaling in thrombo-inflammation. Then, we'll learn about how hemoglobin levels are linked to survival in transfusion-dependent beta-thalassemia. Finally we'll hear about how etoposide is better than its reputation in primary HLH—hemophagocytic lymphohistiocytosis. Symptomatic patients treated with etoposide have substantially better outcomes as compared to the historical experience.
On this episode, we reintroduce you to NinaMaria Badalamenti as our new co-host of Thal Pals. NinaMaria is a patient advocate who has previously appeared on the show. Alongside Dr. Kevin Kuo, the two discuss what's new in thalassemia. SHOW DESCRIPTION Thal Pals: The Alpha Beta Revolution Podcast is intended for patients, caregivers, providers, and the greater community of people who are impacted by Thalassemia. Each episode, Thal Pals strives to provide listeners with critical education, the latest scientific updates, and voices from the Thalassemia community. TRANSPARENCY STATEMENT Thal Pals: The Alpha Beta Revolution Podcast is made possible by Agios Pharmaceuticals Inc. Visit Agios.com to learn more. The following Agios-supported programs are intended for informational and educational purposes only and are not intended as medical advice. Please speak with your healthcare professional before making any treatment decisions. Hosts featured in this episode have been compensated for their time.
Replay: Cooley's Anemia Foundation Family Conference: A Teen Conversation
On this episode we're live in Los Angeles, California from the Cooley's Anemia Foundation family conference. Co-hosts Laurice Levine and Ralph Colasanti host a panel of teenagers in conversation about their unique experiences with thalassemia. To learn more about Cooley's Anemia Foundation, click this link. SHOW DESCRIPTION Thal Pals: The Alpha Beta Revolution Podcast is intended for patients, caregivers, providers, and the greater community of people who are impacted by Thalassemia. Each episode, Thal Pals strives to provide listeners with critical education, the latest scientific updates, and voices from the Thalassemia community. TRANSPARENCY STATEMENT Thal Pals: The Alpha Beta Revolution Podcast is made possible by Agios Pharmaceuticals Inc. Visit Agios.com to learn more. The following Agios-supported programs are intended for informational and educational purposes only and are not intended as medical advice. Please speak with your healthcare professional before making any treatment decisions. Hosts and guests featured in this episode have been compensated for their time.
Erdafitinib for Urothelial Carcinoma, TTFields in NSCLC, AI-Powered Device to Detect Skin Cancer, Casgevy for Beta Thalassemia, HyQvia for CIDP, Physicians' Understanding of FDA Approval Process
For the free course "ChatGPT4 for Medical Writers and Editors," go to learnAMAstyle.com Visit Nascentmc.com/podcast for detailed show notes and links. Erdafitinib for Urothelial Carcinoma: The FDA has fully approved erdafitinib (Balversa) for advanced or metastatic urothelial carcinoma with FGFR3 genetic alterations in adults. This follows its initial accelerated approval and is based on the phase 3 THOR trial results, showing improved survival rates and manageable side effects. Erdafitinib reduced death risk by 36% and had a lower treatment discontinuation rate compared to chemotherapy. TTFields in NSCLC: The FDA is reviewing a premarket approval application for tumor treating fields (TTFields) combined with standard therapies for platinum-resistant non–small cell lung cancer. TTFields, first approved in 2011, disrupt cancer cell division and showed enhanced survival in NSCLC patients when combined with immune checkpoint inhibitors or docetaxel, without increasing systemic toxicities. The FDA's decision is expected in the second half of 2024. AI-Powered Device to Detect Skin Cancer: The FDA has approved the first AI-powered handheld device by DermaSensor for assisting in skin cancer detection. It uses AI-driven spectroscopy for analyzing skin lesions and is based on a study involving over 1000 patients. While not a primary screening tool, it aids in detecting melanoma and other skin cancers, especially in patients over 40, and requires further validation testing. Casgevy for Transfusion-Dependent Beta Thalassemia: The FDA has approved Casgevy (exa-cel), developed by Vertex Pharmaceuticals and CRISPR Therapeutics, for treating transfusion-dependent beta-thalassemia. This follows its approval for sickle cell disease and marks the first CRISPR gene-editing technology application for this condition. The approval came ahead of the anticipated date and follows Bluebird Bio's 2022 approval for a similar gene therapy. HyQvia for CIDP: HyQvia, an immune globulin infusion 10%, has been approved by the FDA for chronic inflammatory demyelinating polyneuropathy (CIDP) in adults. Initially approved for primary immunodeficiency, HyQvia is the only product combining immunoglobulin with hyaluronidase, allowing for monthly subcutaneous infusions. The approval is based on its demonstrated efficacy in preventing neuromuscular disability relapse. Physicians' Understanding of FDA Approval Process: A national survey reveals that many physicians have limited understanding of the FDA's drug and medical device approval processes. Only 41% of the surveyed physicians reported moderate or better comprehension of the drug approval process. Despite believing in the adequacy of FDA standards, there's a call for more rigorous post-marketing studies and enhanced education on FDA processes to avoid misconceptions and inaccurate patient advice.
Divine Intervention Episode 494: Thalassemia and the USMLEs
Thalassemias are very frequently tested on the USMLE exams. In this podcast, I help you understand everything about thalassemias so you’re not stuck mindlessly memorizing details. Definitely helpful for Step 1-3. I also discuss a bunch of mechanistic things that may help you understand some concepts in cardiology. Audio Download
UK becomes 1st country to approve gene therapy treatment for sickle cell, thalassemia
AP correspondent Karen Chammas reports on a new mdeicine approved for Sickle Cell disease in the U.K.
Replay: Dr. Nica Cappellini - Mother of Thalassemia
Dr. Kevin Kuo and Laurice Levine talk to the “mother of Thalassemia” Dr. Nica Cappellini on today's show. SHOW DESCRIPTION Thal Pals: The Alpha Beta Revolution Podcast is intended for patients, caregivers, providers, and the greater community of people who are impacted by Thalassemia. Each episode, Thal Pals strives to provide listeners with critical education, the latest scientific updates, and voices from the Thalassemia community. TRANSPARENCY STATEMENT Thal Pals: The Alpha Beta Revolution Podcast is made possible by Agios Pharmaceuticals Inc. Visit Agios.com to learn more. The following Agios-supported programs are intended for informational and educational purposes only and are not intended as medical advice. Please speak with your healthcare professional before making any treatment decisions. Hosts and guests featured in this episode have been compensated for their time.
Thalassaemia International Federation Guidelines
On this episode, we speak with Dr. Androulla Eleftheriou, the Executive Director of the Thalassaemia International Federation as well as Dr. Khaled Musallam, Chief Research Officer at the Burjeel Hospital at Burjeel Medical City in Abu Dhabi, UAE. We discuss the Thalassaemia International Foundation guidelines on non-transfusion dependent thalassemia. SHOW DESCRIPTION Thal Pals: The Alpha Beta Revolution Podcast is intended for patients, caregivers, providers, and the greater community of people who are impacted by Thalassemia. Each episode, Thal Pals strives to provide listeners with critical education, the latest scientific updates, and voices from the Thalassemia community. TRANSPARENCY STATEMENT Thal Pals: The Alpha Beta Revolution Podcast is made possible by Agios Pharmaceuticals Inc. Visit Agios.com to learn more. The following Agios-supported programs are intended for informational and educational purposes only and are not intended as medical advice. Please speak with your healthcare professional before making any treatment decisions. Hosts and guests featured in this episode have been compensated for their time.
2787: Thalassemia Minor, CBO Protocol Phases, Cystic Acne & Staph, Tracking Hormonal Cycle, DNRS Brain Retraining (HouseCall)
Welcome back to our weekend Cabral HouseCall shows! This is where we answer our community's wellness, weight loss, and anti-aging questions to help people get back on track! Check out today's questions: Toni: I have low thyroid and osteoarthritis with two TKR. I have a genetic form of anemia called thalassemia minor. Could this be the cause gif my problems! I'm 65 post menopausal. I do s 3/2/2 intermittent fasting and have gif a year. 3 16 hours 2 nomad 2 no fasting I try to get sufficient calories during my eating window. Shall I stop for a couple of weeks and start again? Anonymous: Hi Dr Cabral, Thank you for all the work you do! I have SIBO and am doing the CBO protocol and will be doing the "killing" phase for the 90 days followed by the 90 day "repair" phase. During both of these phases do we need to remove dairy, gluten & alcohol completely? I have a celebratory event in the later part of the year and was hoping to enjoy 1-2 cocktails, but unsure if this will ruin the entire protocol. Any advice? Kelsi: hi dr. cabral! thank you i'm advance. ive struggled with mild cystic acne for many years, however, lately ive been getting a couple that somehow turn infected. they get incredibly swollen, have to be lanced and the culture comes back positive for staph infection. i avoid antibiotics at all costs but with staph (as ive listened to every podcast), you've stated this is one occasion that it's necessary…so i do. of course, i take S. bouldarii while on them. i'm just looking for confirmation that i'm on the right path. this is my plan. 21 day detox. CBO protocol / finisher heavy metal detox ive also ordered the stress mood and metabolism test to see my hormone levels. also, am i right to take the antibiotic if i have staph in the future? Julia: Hi Dr Cabral! Just asking because i have been attempting to take an at home hormone blood test that was purchased from another company- before i discovered you. I want to do the test however i have an iud and have no menstruation in order to track where I'm at in my cycle. I started taking ovulation tests to check my LH in attempt to track my cycle but find it is not consistent. Do your blood tests require tracking cycle? Also any tips on finally testing my self! This stemmed from low libido. Im 34 yr old and feel like Im 70 Stacey: Hello Dr. Cabral I hope you are having such a beautiful and blessed day . I have a question on DNRS brain retraining . What's your opinion on this way of healing ? I recently bought the program and going to start once summer vacation is over with . It's 60 minutes a day dedication for at least 6 months so I'm a little intimidated but I've seen so many healing testimonies on it . What do you think about it ? Thank you for tuning into today's Cabral HouseCall and be sure to check back tomorrow where we answer more of our community's questions! - - - Show Notes and Resources: StephenCabral.com/2787 - - - Get a FREE Copy of Dr. Cabral's Book: The Rain Barrel Effect - - - Join the Community & Get Your Questions Answered: CabralSupportGroup.com - - - Dr. Cabral's Most Popular At-Home Lab Tests: > Complete Minerals & Metals Test (Test for mineral imbalances & heavy metal toxicity) - - - > Complete Candida, Metabolic & Vitamins Test (Test for 75 biomarkers including yeast & bacterial gut overgrowth, as well as vitamin levels) - - - > Complete Stress, Mood & Metabolism Test (Discover your complete thyroid, adrenal, hormone, vitamin D & insulin levels) - - - > Complete Food Sensitivity Test (Find out your hidden food sensitivities) - - - > Complete Omega-3 & Inflammation Test (Discover your levels of inflammation related to your omega-6 to omega-3 levels) - - - Get Your Question Answered On An Upcoming HouseCall: StephenCabral.com/askcabral - - - Would You Take 30 Seconds To Rate & Review The Cabral Concept? The best way to help me spread our mission of true natural health is to pass on the good word, and I read and appreciate every review!
Long-term outcomes with pembrolizumab in Hodgkin lymphoma, the “incredible ULK” alleviates β-thalassemia, and recommendations for managing CAR T hematotoxicity
In this week's episode, we'll learn about long-term outcomes with pembrolizumab in relapsed/refractory classical Hodgkin lymphoma. Next, what's behind the accumulation of toxic free alpha-globin in beta-thalassemia? Finally, a road map for managing CAR T cell hematologic toxicity.
Cooley's Anemia Foundation Family Conference: A Teen Conversation
On this episode we're live in Los Angeles, California from the Cooley's Anemia Foundation family conference. Co-hosts Laurice Levine and Ralph Colasanti host a panel of teenagers in conversation about their unique experiences with thalassemia. To learn more about Cooley's Anemia Foundation, click this link. SHOW DESCRIPTION Thal Pals: The Alpha Beta Revolution Podcast is intended for patients, caregivers, providers, and the greater community of people who are impacted by Thalassemia. Each episode, Thal Pals strives to provide listeners with critical education, the latest scientific updates, and voices from the Thalassemia community. TRANSPARENCY STATEMENT Thal Pals: The Alpha Beta Revolution Podcast is made possible by Agios Pharmaceuticals Inc. Visit Agios.com to learn more. The following Agios-supported programs are intended for informational and educational purposes only and are not intended as medical advice. Please speak with your healthcare professional before making any treatment decisions. Hosts and guests featured in this episode have been compensated for their time.
Thalassemia: Perspectives from Thailand with Dr. Vip Viprakasit
SHOW NOTES FOR PODCAST PLAYERS: On this episode, Dr. Kevin Kuo sits down with Suwit Sumponpan, a medical science liaison working with Agios Pharmaceuticals and professor Vip Viprakasit, M.D. to discuss treating thalassemia internationally. Note: a portion of this interview is conducted in Thai. For the English portion, please see the time in the show notes. SHOW DESCRIPTION Thal Pals: The Alpha Beta Revolution Podcast is intended for patients, caregivers, providers, and the greater community of people who are impacted by Thalassemia. Each episode, Thal Pals strives to provide listeners with critical education, the latest scientific updates, and voices from the Thalassemia community. TRANSPARENCY STATEMENT Thal Pals: The Alpha Beta Revolution Podcast is made possible by Agios Pharmaceuticals Inc. Visit Agios.com to learn more. The following Agios-supported programs are intended for informational and educational purposes only and are not intended as medical advice. Please speak with your healthcare professional before making any treatment decisions. Hosts and guest featured in this episode have been compensated for their time.
Managing Thalassemia While Working Full-Time
On this episode, host Laurice Levine sits down with news producer and thalassemia patient NinaMaria Badalamenti to discuss working a full-time job while managing her disease. SHOW DESCRIPTION Thal Pals: The Alpha Beta Revolution Podcast is intended for patients, caregivers, providers, and the greater community of people who are impacted by Thalassemia. Each episode, Thal Pals strives to provide listeners with critical education, the latest scientific updates, and voices from the Thalassemia community. TRANSPARENCY STATEMENT Thal Pals: The Alpha Beta Revolution Podcast is made possible by Agios Pharmaceuticals Inc. Visit Agios.com to learn more. The following Agios-supported programs are intended for informational and educational purposes only and are not intended as medical advice. Please speak with your healthcare professional before making any treatment decisions. Hosts and guest featured in this episode have been compensated for their time.
It has long been considered that iron deficiency does not exist in Thalassemia syndromes, including Thalassemia major as well as Trait (Thal minor). But that is incorrect. Recent studies have shown the occurrence of iron deficiency in patients with Beta-Thalassemia Trait. Iron deficiency anemia (IDA) during pregnancy has been associated with an increased risk of low birth weight, preterm delivery, and perinatal mortality and should be treated with iron supplementation in addition to prenatal vitamins. However, patients with Beta-Thalassemias have been considered to be at risk of iron overload due to alterations in function of hepcidin. So, can pregnant women with Beta-Thalassemia Trait, found on hemoglobinopathy screening, take oral iron supplementation for concomitant iron deficiency anemia? That's a big question, and we're going to answer it in this episode!
On this episode, host Laurice Levine speaks with patient advocates Ralph Colasanti, Rucha Shah and NinaMaria Badalamenti about how different generations of patients have dealt with managing their Thalassemia. SHOW DESCRIPTION Thal Pals: The Alpha Beta Revolution Podcast is intended for patients, caregivers, providers, and the greater community of people who are impacted by Thalassemia. Each episode, Thal Pals strives to provide listeners with critical education, the latest scientific updates, and voices from the Thalassemia community. TRANSPARENCY STATEMENT Thal Pals: The Alpha Beta Revolution Podcast is made possible by Agios Pharmaceuticals Inc. Visit Agios.com to learn more. The following Agios-supported programs are intended for informational and educational purposes only and are not intended as medical advice. Please speak with your healthcare professional before making any treatment decisions. Hosts and guests featured in this episode have been compensated for their time.
On this episode, Dr. Kevin Kuo and Laurice Levine are recording in New Orleans where they take an existential dive into the concept of “disease burden” in Thalassemia. SHOW DESCRIPTION Thal Pals: The Alpha Beta Revolution Podcast is intended for patients, caregivers, providers, and the greater community of people who are impacted by Thalassemia. Each episode, Thal Pals strives to provide listeners with critical education, the latest scientific updates, and voices from the Thalassemia community. TRANSPARENCY STATEMENT Thal Pals: The Alpha Beta Revolution Podcast is made possible by Agios Pharmaceuticals Inc. Visit Agios.com to learn more. The following Agios-supported programs are intended for informational and educational purposes only and are not intended as medical advice. Please speak with your healthcare professional before making any treatment decisions. Hosts and guest featured in this episode have been compensated for their time.




























